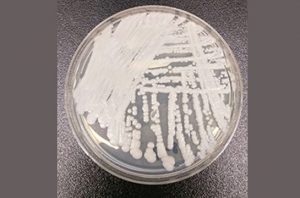

infeksi jamur


Dermatofitosis adalah jenis penyakit yang disebabkan oleh kolonisasi jamur dermatofit yang menyerang jaringan keratin pada manusia. Spesies jamur yang dapat mengakibatkan infeksi kulit tersebut ada banyak, salah satunya Epidermophyton floccosum. […]

Histoplasma capsulatum merupakan sejenis fungi dimorfik yang dapat ditemukan di seluruh dunia, kecuali Arktika. Jamur ini berbiak di permukaan tanah yang mengandung tinja hewan. Sporanya dapat menyebar dan menyebabkan infeksi […]

Tak banyak yang mengetahui, bahwa setidaknya ada 80 spesies jamur yang hidup di dalam tubuh manusia. Jamur-jamur ini sejatinya bersifat alami, eksistensinya tidak berbahaya jika dalam batas wajar. Salah satu […]

Stachybotrys chartarum atau jamur hitam dan jamur hitam beracun, ialah salah satu spesies kapang yang berbiak pada material bangunan lembap. Jenis mikrob ini terkenal cukup berbahaya, sebab dapat menimbulkan penyakit […]

Armillaria mellea merupakan sejenis jamur madu (Armillaria) yang berasal dari keluarga Physalacriaceae. Fungi ini pakar sebut memiliki sifat patogenik, sehingga mampu menghambat dan juga membunuh pertumbuhan suatu tanaman. Jamur madu […]

Petugas kesehatan dan peneliti kini tengah berpacu melawan waktu menghadapi kuman misterius. Kuman tersebut adalah jamur Candida auris, menyerang manusia dengan sistem kekebalan tubuh yang lemah dan kini diam-diam menyebar di seluruh dunia.

Jika melihat film “Resident Evil”, yang terbayang di pikiran kita adalah adanya zombie yang tercipta dari manusia atau makhluk hidup lain yang terinfeksi oleh T-virus. Di kehidupan nyata hal ini […]




















